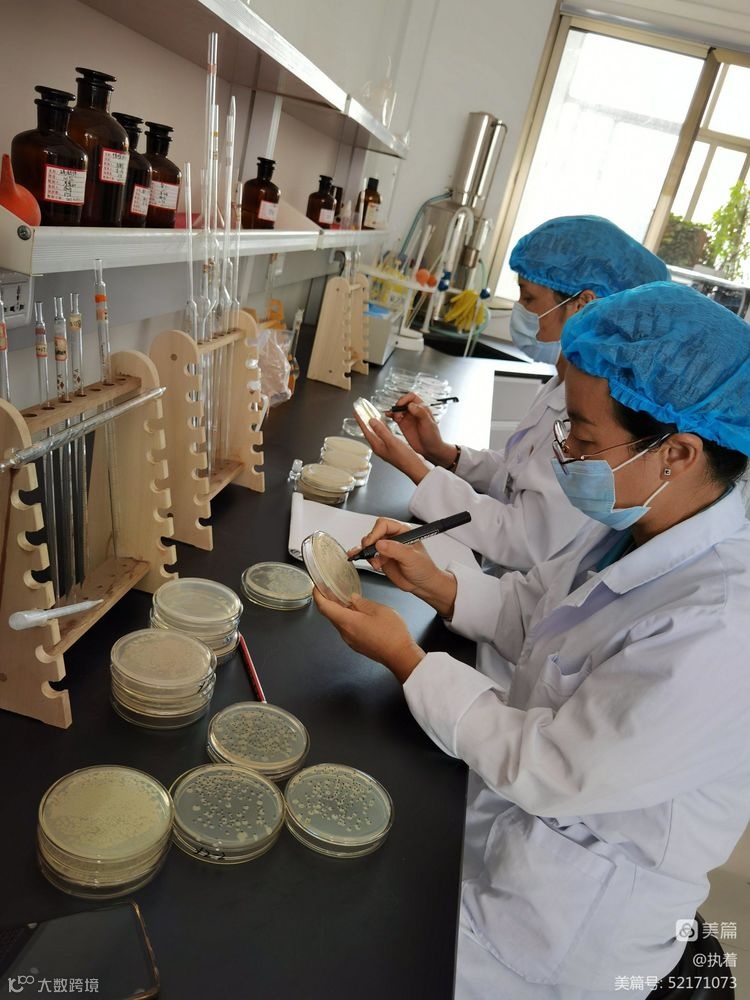

水是生命之源。

好肥出好果!















好肥出好油!















好肥出好米!




















大嫂告诉二嫂,顺丰有机肥料好!
顺丰“洱海”牌有机肥料应该是您最理想的选择!





图/文:顺丰洱海环保股份质量管理部—姚秉蕊
责任编辑:任健霖




